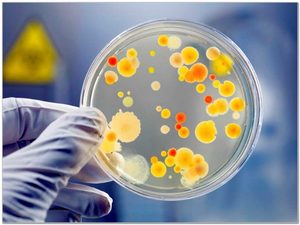
Что такое стафилококк Заболевание стафилококка

Золотистый стафилококк (Staphylococcus aureus) — патогенная бактерия, вызывающая множество инфекционных заболеваний у человека. В последние годы увеличилось количество инфекций, вызванных этим микроорганизмом, что делает его важным объектом исследования. В статье рассмотрим происхождение и историю открытия золотистого стафилококка, его основные формы, симптомы заболеваний, методы диагностики и лечения. Понимание этих аспектов поможет читателям осознать риски инфекций, вызванных золотистым стафилококком, и принять меры для их предотвращения и эффективного лечения.
Всё, что нужно знать о бактериях
Это одни из самых древних организмов на нашей планете, появившихся, вероятно, более трех с половиной миллиардов лет назад, в архейскую эру. Бактерии оставались единственными живыми существами на протяжении двух с половиной миллиардов лет и сыграли ключевую роль в формировании атмосферы Земли, синтезируя кислород и азот. Их значение в образовании почвы, а также в жизни растений и животных невозможно переоценить.
Мир бактерий был впервые открыт в XVII веке голландским самоучкой Антонием ван Левенгуком. Этот шлифовальщик стеклянных линз, обладавший выдающейся фантазией и терпением, проявлял живой интерес к «противным существам», как он их называл, изучая их в капле воды с помощью увеличительных стеклянных линз, увеличивающих в 200 раз. Левенгук тщательно фиксировал результаты своих наблюдений, что позволило ему, не имея образования и не зная латыни, завоевать признание среди ученых благодаря открытию царства бактерий, о существовании которых до него никто не догадывался.
Существуют как подвижные, так и неподвижные формы бактерий. Подвижные организмы могут перемещаться благодаря сокращениям в виде волн, с помощью жгутиков — специальных белковых структур, напоминающих скрученные нитки или винтики, или же за счет скольжения по слизи, которую они выделяют. Кроме того, подвижные почвенные и водные бактерии могут регулировать содержание азота в вакуолях своей цитоплазмы, что позволяет им подниматься или опускаться в водной или почвенной среде.
Бактерии отличаются простотой своего строения и неприхотливостью к условиям существования, что и обеспечивает их повсеместное распространение. Они обитают в воде, почве, воздухе, камнях, песке пустынь, снегу и льду на полюсах, на дне океана, в нефти и горячих подземных источниках — везде можно встретить эти микроорганизмы. Их удивительная выносливость и способность адаптироваться к неблагоприятным условиям позволяют бактериям сохранять жизнеспособность при сильном охлаждении, нагреве, замораживании или высушивании. Они могут проникать через мельчайшие отверстия и щели благодаря своему микроскопическому размеру. В почве их количество может достигать сотен миллионов на один грамм. Некоторые виды способны существовать без воздуха, а другие могут подниматься на высоту до 25 км и более над уровнем земли.
Бактерии проникают в организм из окружающей среды, с поверхности кожи или уже живут внутри, принося пользу, помогая перевариванию пищи и вырабатывая витамины.
Руки человека, а также ротовая полость и горло чаще всего становятся входными воротами для микробов. Даже полностью здоровый человек является носителем микроорганизмов. Наиболее распространенным является сочетание золотистого стафилококка и различных видов грибов.
Врачи отмечают, что золотистый стафилококк является одним из наиболее распространенных патогенов, вызывающих инфекции у взрослых. Симптомы могут варьироваться от легких кожных проявлений, таких как фурункулы и карбункулы, до более серьезных состояний, включая пневмонию и сепсис. Важно, что клиническая картина может быть разнообразной, и иногда инфекция протекает бессимптомно, что затрудняет диагностику.
Специалисты подчеркивают необходимость своевременного обращения к врачу при первых признаках инфекции. Лечение обычно включает антибиотики, однако устойчивость стафилококка к некоторым из них может потребовать применения более мощных препаратов. Врачи также рекомендуют соблюдать меры профилактики, такие как регулярная гигиена и обработка ран, чтобы снизить риск заражения. Своевременная диагностика и адекватное лечение играют ключевую роль в успешной борьбе с этой инфекцией.
https://youtube.com/watch?v=ARu6i7bxOWY
Золотистый стафилококк: что это такое
Стафилококк представляет собой неподвижный шарообразный микроорганизм диаметром примерно 1 микрометр. Эти бактерии могут находиться поодиночке, парами, образовывать короткие цепочки или собираться в гроздья. Такое строение дало основание для их названия, которое происходит от сочетания двух греческих слов: стафула — виноград и коккос — зерно.
Не образующие спор и не требовательные к условиям, золотистые стафилококки лучше всего развиваются при температуре человеческого тела: 34–37 °C. Эти микроорганизмы обладают высокой устойчивостью к неблагоприятным факторам, таким как высушивание и воздействие дезинфицирующих средств. Кроме того, стафилококки способны развивать резистентность к антибиотикам и антимикробным препаратам.
С давних пор эти микроорганизмы были признаны возбудителями инфекционных заболеваний у человека. В настоящее время, на фоне увеличения случаев и заболеваний, сопровождающихся ослаблением иммунной системы, особую опасность представляют больничные инфекции, которые могут возникать как в ходе хирургического, так и терапевтического лечения пациентов в стационаре. В этой ситуации стафилококки занимают второе место по распространенности среди возбудителей внутрибольничных инфекций, и их лечение представляет собой серьезную задачу.
| Аспект | Описание | Лечение |
|---|---|---|
| Общая информация | Бактерия Staphylococcus aureus, часто обитает на коже и слизистых. Может вызывать широкий спектр инфекций. | Зависит от типа инфекции и чувствительности к антибиотикам. |
| Пути передачи | Контактный (через руки, предметы), воздушно-капельный (реже), через пищу. | Профилактика: гигиена рук, обработка ран. |
| Факторы риска | Ослабленный иммунитет, хронические заболевания, повреждения кожи, хирургические вмешательства, использование катетеров. | Устранение факторов риска, укрепление иммунитета. |
| Кожные инфекции | Фурункулы, карбункулы, импетиго, целлюлит, абсцессы. | Антибиотики (местно или системно), дренирование абсцессов, антисептическая обработка. |
| Инфекции дыхательных путей | Пневмония, синусит, тонзиллит. | Антибиотики (системно), симптоматическое лечение. |
| Инфекции костей и суставов | Остеомиелит, септический артрит. | Длительный курс антибиотиков (внутривенно), хирургическое вмешательство. |
| Инфекции кровотока (сепсис) | Бактериемия, септический шок. | Интенсивная терапия, внутривенные антибиотики, поддержка жизненно важных функций. |
| Токсический шок | Редкое, но тяжелое состояние, вызванное токсинами стафилококка. | Интенсивная терапия, антибиотики, иммуноглобулины. |
| Диагностика | Бактериологический посев (кровь, моча, раневое отделяемое), ПЦР. | Выявление возбудителя и его чувствительности к антибиотикам. |
| Антибиотикорезистентность | Распространение метициллин-резистентного золотистого стафилококка (MRSA). | Использование антибиотиков резерва, индивидуальный подбор терапии. |
| Профилактика | Гигиена рук, обработка ран, избегание контакта с инфицированными, вакцинация (в разработке). | Соблюдение санитарных норм, укрепление здоровья. |
Болезни и патологические состояния, вызываемые стафилококком
- Гнойные инфекции, как поверхностного, так и глубокого характера;
- Инфекции мочевыводящих путей;
- Сепсис, или инфекция крови;
- Воспалительные процессы в сосудах, эндокардит, вызванные стафилококком;
- Инфекции раневой поверхности в послеоперационный период;
- Инфицирование при установке суставных протезов;
- Остеомиелит, миозит, гнойный артрит и бурсит, вызванные стафилококковыми бактериями;
- Пищевые отравления микробного происхождения, стафилококковый токсикоз;
- Стафилодермии при атопическом дерматите как сопутствующая инфекция;
- Фурункулёз как осложнение дерматита;
- Карбункул с присоединением стафилококковой инфекции;
- Гидраденит, то есть воспаление потовых желез;
- Абсцесс и стафилококковая флегмона;
- Фолликулит и остеофолликулит (гнойное инфекционное поражение волосяного фолликула);
- Токсический шок, возникающий после использования вагинальных тампонов или как осложнение после родов, абортов, барьерной контрацепции, послеоперационных ран, укусов насекомых, ветряной оспы, химических или термических ожогов, повреждений кожи и т.д.;
- Стафилококковый дерматит как самостоятельное заболевание;
- Болезнь Риттера, или синдром ошпаренной кожи при стафилококковой инфекции;
- Стафилококковая ангина и другие проявления стафилококковой инфекции в области горла;
- Пневмония;
- Стафилококковый абсцесс головного мозга, эпидуральный абсцесс, гнойный менингит.
Золотистый стафилококк является одной из самых распространённых бактериальных инфекций кожи и слизистых оболочек у человека и представляет собой значительную сложность в лечении, несмотря на то что его диагностика давно отработана и успешна. Симптоматика стафилококковой инфекции хорошо известна и типична. У взрослых проявления стафилококка менее выражены и не так ярко выражены, как у детей. Тем не менее, признаки стафилококковой инфекции остаются довольно характерными.
https://youtube.com/watch?v=HIOP4IOkqO4
Как проявляется стафилококк у взрослых?
Для правильной диагностики наиболее эффективным методом является проведение бактериологического посева. Стафилококковая инфекция в горле выявляется по мазкам из зева или носа, особенно при наличии болей в горле или синуситах.
Клинические проявления, характерные для стафилококковой ангины и других инфекций горла, включают следующие симптомы стафилококка в ротовой полости:
- болезненность при глотании,
- покраснение и сыпь на коже, напоминающая скарлатину,
- увеличение миндалин во рту,
- ощущение сухости в горле,
- отёк, покраснение, разрыхление и изъязвление слизистой оболочки ротоглотки,
- увеличение и болезненность подчелюстных лимфоузлов при пальпации,
- затруднённое носовое дыхание,
- повышение температуры тела,
- ощущение ломоты в теле,
- общая слабость, головная боль и другие признаки интоксикации.
Стафилококковый дерматит обычно развивается на фоне уже имеющихся кожных заболеваний, которые ослабляют иммунную систему. Микрофлора человеческого организма может быть причиной таких заболеваний, и они часто начинаются с воспаления волосяного фолликула или области вокруг ногтей.
Носительство золотистого стафилококка представляет собой своего рода мину замедленного действия. Микроорганизмы, находясь на коже, слизистых оболочках и внутри организма, не вызывают заболеваний. Однако при травмах, ранениях или снижении иммунной защиты организма патогенные микробы могут активироваться и приводить к серьёзным состояниям, которые порой сложно лечить.
Лечение золотистого стафилококка у взрослых
Гнойные инфекции, вызванные золотистым стафилококком, требуют лечения, которое включает в себя дренирование раны для удаления гноя. Важно также извлечь инородные тела, вокруг которых образовалось нагноение, такие как эндопротезы или костные отломки. Необходимо вскрыть гнойник и удалить некротические ткани. В большинстве случаев, при лечении кожных инфекций, достаточно вскрытия гнойника и его дренирования для облегчения состояния пациента. Кроме того, требуется назначение антибиотиков, направленных на уничтожение золотистого стафилококка.
Однако лечение стафилококковых инфекций антибиотиками сталкивается с проблемой быстрой выработки устойчивости этих микроорганизмов к медикаментам. Уже через четыре года после открытия пенициллина были выявлены штаммы золотистого стафилококка, устойчивые к этому препарату. С тех пор продолжается борьба: ученые разрабатывают новые антибиотики, а бактерии быстро адаптируются к ним. Кто выйдет победителем в этой гонке, покажет время…
На данный момент для лечения стафилококка в полости рта и устранения симптомов активно используется полоскание раствором хлорофиллипта. Для облегчения боли в ротовой полости хорошо подходят отвары и настои лекарственных трав, которые помогают снизить воспаление и улучшить общее состояние пациента. Важно помнить, что все назначения должен делать врач на основе анализа симптомов. Лечение должно проводиться специалистом, так как самолечение может привести к негативным последствиям.
Если золотистый стафилококк обнаружен в крови, требуется интенсивное внутривенное введение антибиотиков в условиях стационара.
При остеомиелите и воспалительных процессах в костной, суставной и мышечной системах также может потребоваться госпитализация и применение соответствующих антибактериальных средств.
Кроме вышеперечисленных мероприятий, пациенту необходима витаминотерапия и действия, направленные на восстановление иммунной системы, пострадавшей от болезни.
Имеет смысл заниматься борьбой с носительством золотистого стафилококка, выясняя местонахождение резервуара возбудителя. Обычно это носоглотка или раневая поверхность при наличии хронических незаживающих ран, а также кожа и мягкие ткани подкожной клетчатки.
Особое внимание следует уделять профилактике распространения стафилококковой инфекции. Проблема частых вспышек внутрибольничных инфекций имеет глобальное значение и затрагивает даже самые известные клиники и больницы. По статистике, чаще всего заражение происходит через руки медицинского персонала, поэтому применяются строгие меры контроля за чистотой и соблюдением норм обработки рук медиков.
Необходимо помнить, что эпителий кожи и слизистых оболочек служит естественным барьером для золотистого стафилококка. Если эпителий не поврежден, протоки сальных и потовых желез не закупорены, а волосяные фолликулы не воспалены, бактерии не смогут преодолеть этот барьер, и заболевание не возникнет.
https://youtube.com/watch?v=1MN3a4McJhg
Профилактика инфекций, вызванных золотистым стафилококком
Профилактика инфекций, вызванных золотистым стафилококком, играет ключевую роль в снижении заболеваемости и предотвращении распространения этого патогена. Золотистый стафилококк (Staphylococcus aureus) является частью нормальной микрофлоры кожи и слизистых оболочек человека, однако при определенных условиях он может вызывать серьезные инфекции. Для минимизации риска заражения следует учитывать несколько важных аспектов.
1. Личная гигиена: Соблюдение правил личной гигиены является основным способом предотвращения инфекций. Регулярное мытье рук с мылом, особенно после посещения общественных мест, а также перед едой и после контакта с животными, значительно снижает риск передачи бактерий. Важно также поддерживать чистоту кожи, избегая повреждений и травм, которые могут стать входными воротами для инфекции.
2. Обработка ран: Все повреждения кожи, такие как порезы, ссадины и ожоги, необходимо обрабатывать антисептическими средствами и закрывать стерильными повязками. Это поможет предотвратить попадание стафилококков в организм и развитие инфекции. В случае появления признаков воспаления (покраснение, отек, гной) следует обратиться к врачу.
3. Избегание контакта с инфицированными: Золотистый стафилококк может передаваться от человека к человеку, поэтому важно избегать близкого контакта с людьми, у которых есть активные инфекции, особенно кожные. В общественных местах, таких как спортзалы или бассейны, следует соблюдать осторожность и использовать индивидуальные принадлежности.
4. Укрепление иммунной системы: Здоровый образ жизни, включая сбалансированное питание, регулярные физические нагрузки и достаточный сон, способствует укреплению иммунной системы. Это, в свою очередь, помогает организму более эффективно бороться с инфекциями, в том числе и вызванными золотистым стафилококком.
5. Вакцинация: Хотя на данный момент не существует специфической вакцины против золотистого стафилококка, вакцинация против других инфекционных заболеваний (например, гриппа и пневмококковой инфекции) может снизить общее бремя инфекционных заболеваний и укрепить иммунный ответ организма.
6. Контроль за хроническими заболеваниями: Люди с хроническими заболеваниями, такими как диабет или заболевания легких, имеют повышенный риск развития инфекций. Поэтому важно контролировать эти состояния и следовать рекомендациям врачей для снижения риска осложнений.
Соблюдение этих простых, но эффективных мер профилактики поможет значительно снизить риск инфекций, вызванных золотистым стафилококком, и сохранить здоровье. Важно помнить, что при первых признаках инфекции необходимо обратиться к врачу для получения квалифицированной медицинской помощи.
Диагностика стафилококковых инфекций
Диагностика стафилококковых инфекций, вызванных золотистым стафилококком (Staphylococcus aureus), представляет собой сложный и многоступенчатый процесс, который требует внимательного подхода и использования различных методов. Основная задача диагностики заключается в выявлении патогена, оценке его чувствительности к антибиотикам и определении тяжести инфекции.
Первым этапом диагностики является сбор анамнеза. Врач должен выяснить, когда появились первые симптомы, какие факторы могли способствовать инфицированию (например, наличие открытых ран, хирургические вмешательства, ослабленный иммунитет), а также наличие контактов с другими людьми, у которых могут быть аналогичные симптомы.
Клинические проявления стафилококковой инфекции могут варьироваться от легких кожных высыпаний до тяжелых системных заболеваний. Наиболее распространенные симптомы включают:
- кожные инфекции (фурункулы, карбункулы, импетиго);
- пневмонию;
- остеомиелит;
- эндокардит;
- сепсис.
Для подтверждения диагноза проводятся лабораторные исследования. Основным методом является бактериологический посев. Для этого из пораженной области (кожи, крови, мокроты и т.д.) берется образец, который помещается на питательную среду. После инкубации в условиях, способствующих росту бактерий, исследуется полученная культура на наличие золотистого стафилококка.
Кроме того, могут использоваться молекулярно-генетические методы, такие как ПЦР (полимеразная цепная реакция), которые позволяют быстро и точно выявить ДНК патогена в образцах. Эти методы особенно полезны в случаях, когда традиционные культуры не дают результатов, например, при наличии антибиотикорезистентных штаммов.
Также важно провести тесты на чувствительность к антибиотикам, чтобы определить, какие препараты будут наиболее эффективными для лечения. Это особенно актуально в свете растущей проблемы антибиотикорезистентности, когда некоторые штаммы золотистого стафилококка становятся устойчивыми к стандартным антибиотикам.
В некоторых случаях может потребоваться дополнительная визуализация, такая как рентгенография или УЗИ, для оценки распространенности инфекции, особенно если есть подозрение на вовлечение внутренних органов.
Таким образом, диагностика стафилококковых инфекций требует комплексного подхода, включающего сбор анамнеза, клиническое обследование, лабораторные исследования и, при необходимости, дополнительные методы визуализации. Это позволяет не только подтвердить наличие инфекции, но и выбрать оптимальную стратегию лечения для каждого конкретного пациента.
Рекомендации по восстановлению после инфекции
После перенесенной инфекции, вызванной золотистым стафилококком, важно уделить внимание восстановлению организма. Это поможет не только ускорить процесс заживления, но и снизить риск рецидивов. Ниже представлены основные рекомендации, которые помогут в восстановлении.
1. Соблюдение режима отдыха
После болезни организму требуется время для восстановления. Рекомендуется соблюдать режим сна и отдыха, чтобы дать возможность иммунной системе восстановиться. Спите не менее 7-8 часов в сутки, а также выделяйте время для дневного отдыха.
2. Правильное питание
Сбалансированное питание играет ключевую роль в восстановлении. Включите в рацион продукты, богатые витаминами и минералами, такие как:
- Фрукты и овощи (особенно цитрусовые, ягоды, шпинат, брокколи);
- Белковые продукты (мясо, рыба, яйца, бобовые);
- Цельнозерновые продукты (овсянка, гречка, киноа);
- Молочные продукты (йогурты, кефир, творог).
Также важно поддерживать водный баланс, употребляя достаточное количество жидкости, что поможет организму выводить токсины и ускорить процесс восстановления.
3. Укрепление иммунной системы
Для повышения иммунной защиты рекомендуется:
- Регулярно заниматься физической активностью (умеренные физические нагрузки способствуют улучшению кровообращения и укреплению иммунитета);
- Избегать стрессов и находить время для релаксации (медитация, йога, прогулки на свежем воздухе);
- При необходимости принимать витамины и минералы, особенно витамин C, D и цинк, после консультации с врачом.
4. Соблюдение гигиенических норм
Золотистый стафилококк может оставаться в организме даже после лечения, поэтому важно соблюдать правила личной гигиены:
- Регулярно мыть руки с мылом, особенно после посещения общественных мест;
- Избегать контакта с людьми, у которых есть открытые раны или инфекции;
- Поддерживать чистоту в доме, особенно в местах, где вы проводите много времени.
5. Регулярные медицинские осмотры
После перенесенной инфекции рекомендуется проходить регулярные медицинские осмотры. Это позволит контролировать состояние здоровья и при необходимости вовремя выявлять возможные осложнения или рецидивы инфекции.
Следуя данным рекомендациям, вы сможете значительно ускорить процесс восстановления после инфекции, вызванной золотистым стафилококком, и улучшить общее состояние здоровья.